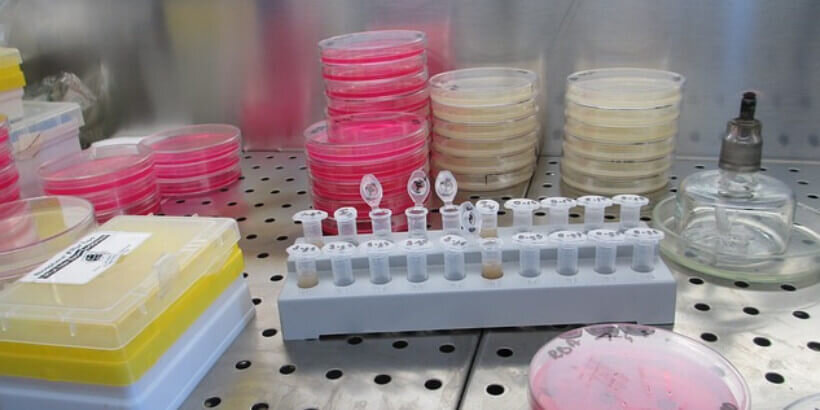
test tubes on table

DIG IN
The latest articles from Chelsea Green and our authors: offering tips and techniques about how you can bring our books to life in your kitchen, backyard, or community.
Choosing the Best Heat Source for Your Greenhouse
When it comes to heating your greenhouse, the options may seem endless and expensive. Fear not! Growing your own food in the cold weather doesn’t have to break the bank. The best solution differs from farm to farm; it depends on the climate, crops grown, and the greenhouse structure itself. Harness the advancements in greenhouse…
Read MoreThe Importance of Imagination
From What Is to What If author Rob Hopkins is a co-founder of Transition Town Totnes and Transition Network. He is also the author of The Power of Just Doing Stuff, The Transition Handbook, and The Transition Companion. He earned a spot on Nesta and the Observer’s list of Britain’s 50 New Radicals and was…
Read MoreHappy National Cookbook Month!
From foraging to fermenting, a good cookbook can be the guiding force that elevates your culinary skills. Draw a little inspiration from our expert chefs, foragers, and brewers and get ready to kickstart your own creativity in the kitchen! With recipes for gumbos and stews, plus okra pickles, tofu, marshmallow, paper, and more The Whole…
Read MoreBuilding Strength by Mastering Hunger
“How can we expect to feel our best unless we live in harmony with the way our bodies work?” —Denis Wilson, MD In the United States, more than 35 percent of adults and nearly 17 percent of children are obese. This is true in spite of our cultural obsession with diets, exercise fads, and health…
Read MoreSpeaking for the Bees
“Having a relationship with the rest of nature is knowing that we can, if we wish, rekindle our lost connections, because somewhere deep inside us all, there lives a little spark of ‘wild’ just waiting to be ignited.” —Brigit Strawbridge Howard Our planet is home to at least 20,000 species of bees—a statistic most of…
Read MoreWhat is Water?
Since his bout with throat cancer, ForeWord Editor-in-Chief Matt Sutherland has been hot to discover the most reputable integrative health and wellness books that address alternative approaches to cancer prevention and treatment. Cancer and the New Biology of Water is one of these books. The following is an excerpt from Sutherland’s interview with Thomas Cowan…
Read MoreThe Terrifying Diagnosis: Where Do We Go from Here?
Cancer is a terrifying diagnosis for many people and their loved ones. While the medical community has made immense progress in treating it, there are still a lot of uncertainties. The biggest being that even after years of research, there is still no cure. Each question we answer only leads to a new one, adding…
Read MoreBack-to-the-Land Dreams
These days, becoming a farmer isn’t considered a “typical” career path. But for some folks, the allure of cultivating your food and owning your land seems too good to resist. These people were born to return to nature, where they can experience true freedom in the open air. The following is an excerpt from Going…
Read MoreThe Story and Legacy of a Radical Industrialist and his Quest for Authentic Change
Ray C. Anderson’s Mid-Course Correction, originally published 20 years ago, became the definitive case study for sustainable business. Now fully updated and expanded for the twenty-first century, Mid-Course Correction Revisited includes new chapters penned by Anderson’s grandson, John A. Lanier. The following is an excerpt from Mid-Course Correction Revisited by Ray Anderson & John Lanier.…
Read MoreA New Culture in Health Care
In the face of the American healthcare crisis, some companies have acknowledged the system’s effect on employee productivity and made healthcare reformation a priority. Amazon, JPMorgan Chase, and Berkshire Hathaway built a joint health care venture to re-examine insurance benefits, access to primary care, and pharmaceutical costs. Finding the right person to take the lead…
Read MoreVegan Apple Honey Cake
Oy Vey Vegan explores the plant-based food world with a concentration in Mediterranean and Jewish Eastern European flavor influences. Estee Raviv creates a variety of options from breakfast to dinner to snacks and desserts that disprove the common thought of vegan food being bland. This cookbook is for everyone—from beginners to master chefs to curious…
Read MoreHappy Pigs Really Do Taste Better
For ten years Alice Percy operated a commercial hog operation on her farm in Whitefield, Maine, becoming the largest certified hog producer in the state. Percy has mentored hog farming startups through the Maine Organic Farmers and Gardeners Association (MOFGA), and helped to develop the association’s Raising Organic Pigs fact sheet. She has presented workshops…
Read MoreThe Power of Nonviolent Direct Action
Some acts of nonviolent protesting put the message out for the public and brings attention to the issue. However, this strategy doesn’t always capture the attention of the people who have the power—the government. Adding strategy to nonviolence brings the attention it needs directly into the face of those who can change the rules and…
Read MoreWhy Isn’t Farming Enough?
Years ago family farms were an abundance. Generations of farmers passed the land down in hopes of it continuing to prosper. However, these farms are a rarity; smaller ones are put out of business by large corporations and the cost of maintenance yields no profit. Many farmers have to find other means of making a…
Read MoreResilience and the Lost Art of Agricultural Inventiveness
After twenty years in academia, Michael Foley began farming first in southern Maryland, and then in Willits, California, where he, his wife, and oldest daughter currently operate the small, diversified Green Uprising Farm. Foley is cofounder of the School of Adaptive Agriculture, a farmer training and education program where he is a board member and…
Read MoreDIY Fecal Transplant: Pretty Close to Miraculous
Fecal transplants are a relatively new procedure that transfers healthy feces into the colon of someone who needs a probiotic ecosystem of good bacteria.
Read MoreRethinking Pests, Invasive Species, and Other Paradigms
At the first sight of small chew marks on leaves or fruit mysteriously disappearing, you’ll want to get rid of the pest to protect your crop. Your first instinct might be to use pesticides or other forms of extermination. You can save yourself and your crops from using harmful methods by preparing and managing your…
Read MoreHope for a Thirsty World
Judith D. Schwartz is a journalist whose recent work looks at soil as a hub for multiple environmental, economic, and social challenges and solutions. She writes on this theme for numerous publications and speaks at venues around the world. Her 2013 book Cows Save the Planet was awarded a Nautilus Book Award Silver Prize for…
Read MoreRecipe: Rainbow Beet and Carrot Salad with Garden Herbs
What’s better than eating food that tastes delicious? Eating food that tastes AND looks delicious! Beets and carrots are the secret ingredients to liven up your salad. Combine these colorful vegetables and fresh herbs to create a salad that tastes like spring. This excerpt is fromThe Occidental Arts and Ecology Center Cookbook by The Occidental…
Read More